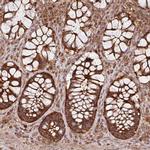
MRRF Antibody in Immunohistochemistry (IHC)

Search
Invitrogen
MRRF Polyclonal Antibody
{{$productOrderCtrl.translations['antibody.pdp.commerceCard.promotion.promotions']}}
{{$productOrderCtrl.translations['antibody.pdp.commerceCard.promotion.viewpromo']}}
{{$productOrderCtrl.translations['antibody.pdp.commerceCard.promotion.promocode']}}: {{promo.promoCode}} {{promo.promoTitle}} {{promo.promoDescription}}. {{$productOrderCtrl.translations['antibody.pdp.commerceCard.promotion.learnmore']}}
产品信息
PA5-61458
种属反应
宿主/亚型
分类
类型
抗原
偶联物
形式
浓度
规格
纯化类型
保存液
内含物
保存条件
运输条件
RRID
产品详细信息
Immunogen sequence: ALGLKCFRMV HPTFRNYLAA SIRPVSEVTL KTVHERQHGH RQYMAYSAVP VRHFATKKAK AKGKGQSQTR VNINAALVED IINLEEVNEE MKSV
Highest antigen sequence identity to the following orthologs: Mouse - 74%, Rat - 71%.
靶标信息
Responsible for the release of ribosomes from messenger RNA at the termination of protein biosynthesis. May increase the efficiency of translation by recycling ribosomes from one round of translation to another. Ota T., Nat. Genet. 36:40-45(2004). Humphray S.J., Nature 429:369-374(2004). Zhang Y., Biochim. Biophys. Acta 1443:245-250(1998).
仅用于科研。不用于诊断过程。未经明确授权不得转售。
篇参考文献 (0)
生物信息学
蛋白别名: Ribosome-recycling factor, mitochondrial; Ribosome-releasing factor, mitochondrial; RRF; unnamed protein product
基因别名: MRFF; MRRF; MTRRF; RRF
UniProt ID: (Human) Q96E11
Entrez Gene ID: (Human) 92399